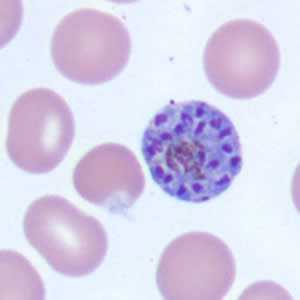

Case #171 - January, 2006
Recently DPDx telediagnosis inquiries received a request for assistance from the Medical College of Wisconsin. Images from a thin blood smear were submitted along with the patient’s history of traveling to Honduras. Figures A-E show what was seen on the thin blood film. What is your diagnosis? Based on what criteria?

Figure A

Figure B

Figure C
Figure D
Case Answer
This was a case of malaria caused by Plasmodium vivax. Diagnostic features are:
- sturdy ring forms (Figures B and C).
- amoeboid developing trophozoites (Figure A).
- the presence of Schüffner’s dots (Figure A).
- a schizont in an enlarged red blood cell with greater than fifteen merozoites (Figure D).
More patient information was provided later and gave the patient’s symptoms as fevers, chills, night sweats, and malaise that started several weeks after returning from vacation in Honduras. The patient reported to the attending physician that malaria prophylaxis was taken prior to and during the trip but discontinued upon return to the United States.
More on: Malaria
This case and images were kindly contributed by the Medical College of Wisconsin.
Images presented in the monthly case studies are from specimens submitted for diagnosis or archiving. On rare occasions, clinical histories given may be partly fictitious.
DPDx is an education resource designed for health professionals and laboratory scientists. For an overview including prevention and control visit www.cdc.gov/parasites/.
- Page last reviewed: August 24, 2016
- Page last updated: August 24, 2016
- Content source:
- Global Health – Division of Parasitic Diseases and Malaria
- Notice: Linking to a non-federal site does not constitute an endorsement by HHS, CDC or any of its employees of the sponsors or the information and products presented on the site.
- Maintained By:


 ShareCompartir
ShareCompartir